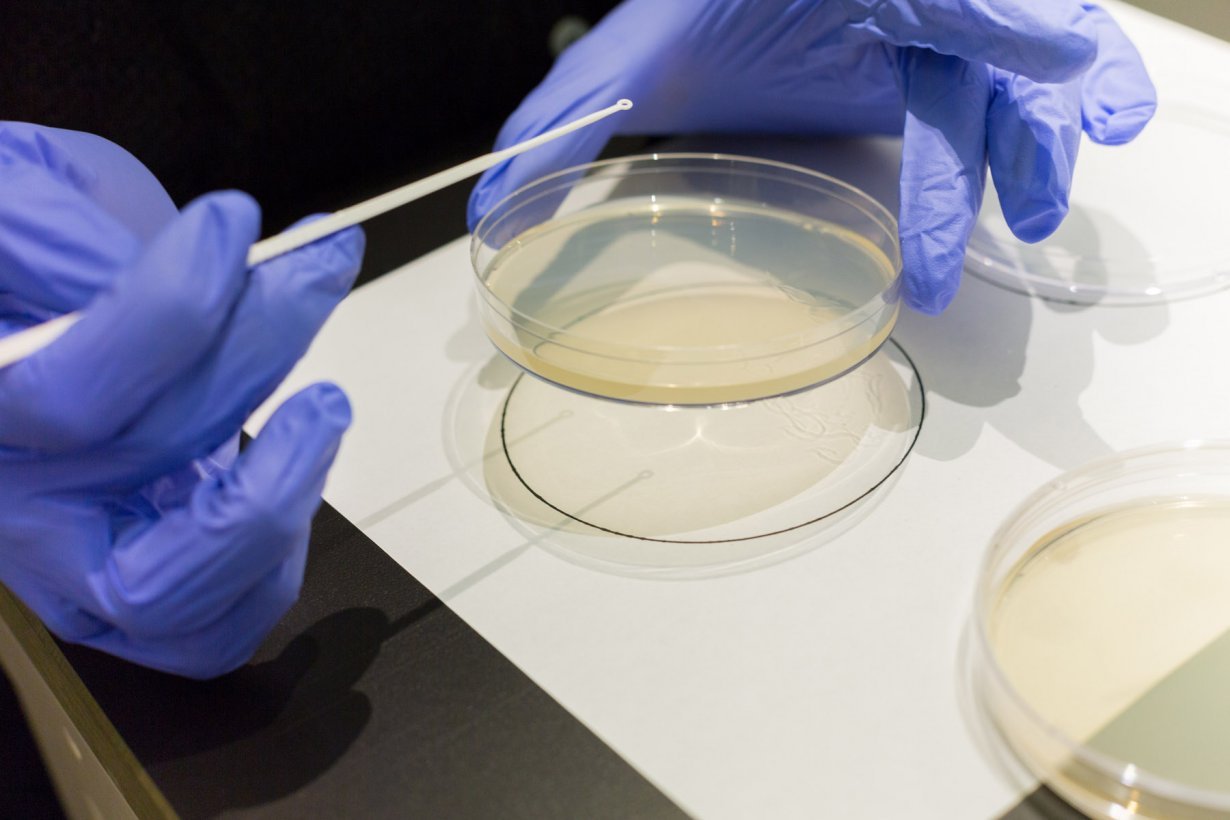
Agar Art Painting With Bacteria Workshop March 1 3 2018 Events
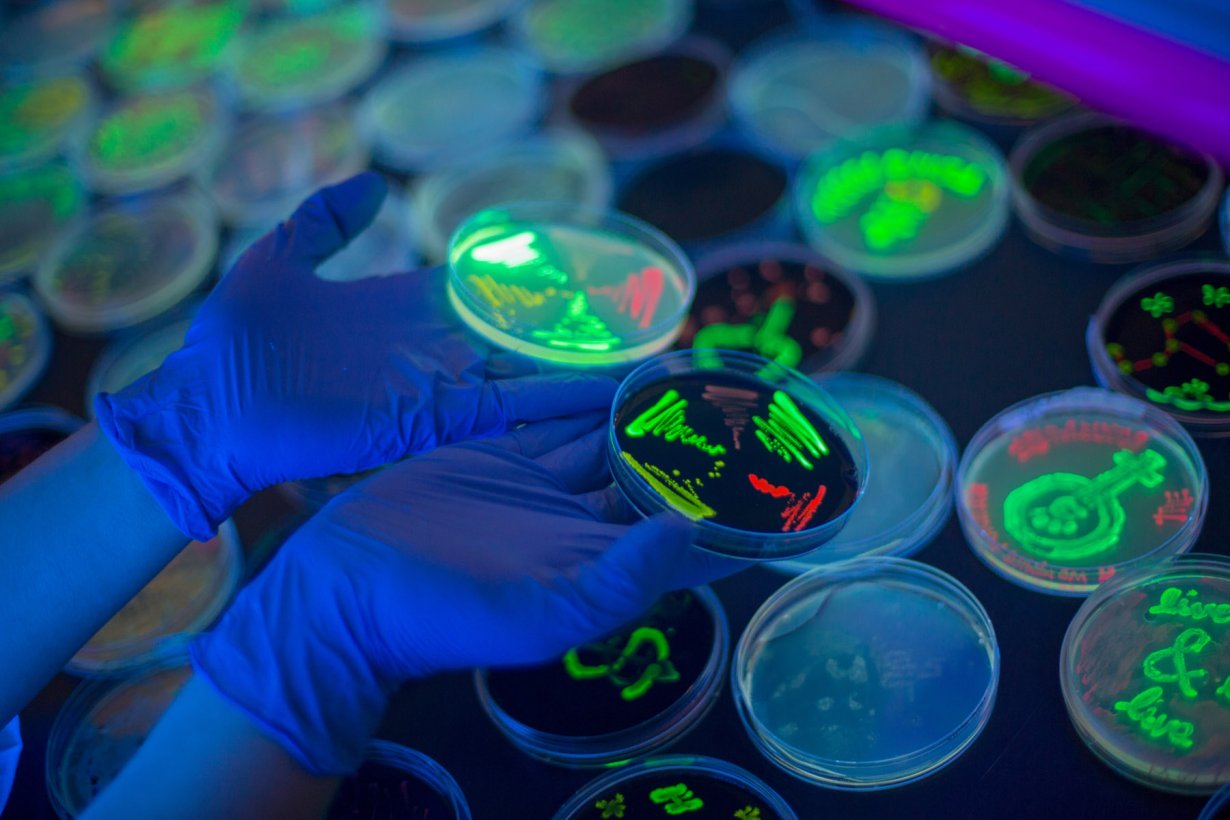
Agar Art Painting With Bacteria Workshop March 1 3 2018 Events

Agar Art Painting With Bacteria Workshop Sva

Agar Art Painting With Bacteria Workshop March 1 3 2018 Events Create your own agar art using live microbes in this two part, hands on workshop, presented by bfa fine arts. Have you ever seen art created in a petri dish using living, growing microorganisms? that's agar art! asm's annual agar art contest is a chance for you to use science to show off your creative skills.

Agar Art Painting With Bacteria Workshop March 1 3 2018 Events There are countless ways to bring art into the science classroom—but what if students could “paint” with living organisms? in the two session mini course picassos in the laboratory: creating agar art in the classroom, mƒa master teachers gilbert papagayo and brittany klimowicz invited teachers to explore bacterial transformation, protein structure, and recombinant dna through an. In this two part, hands on workshop, you will create your own agar art using live microbes. photos of the agar art created in this workshop are eligible to enter the american society of microbiology contest!. Paint with invisible living cells (yeast) and watch as your art grows over the next few days. fun, engaging, and memorable, this simple, evidence backed science art (sci art) activity excites audiences of all ages. To grow microorganisms such as bacteria or fungi, a growth medium like agar is required. there are various types of agar, including general agar such as nutrient agar (na), and specific agar such as triple sugar iron (tsi) agar. in this workshop, na and eosin methylene blue (emb) agar were used.

Agar Art Painting With Bacteria Workshop March 1 3 2018 Events Paint with invisible living cells (yeast) and watch as your art grows over the next few days. fun, engaging, and memorable, this simple, evidence backed science art (sci art) activity excites audiences of all ages. To grow microorganisms such as bacteria or fungi, a growth medium like agar is required. there are various types of agar, including general agar such as nutrient agar (na), and specific agar such as triple sugar iron (tsi) agar. in this workshop, na and eosin methylene blue (emb) agar were used. Microbiologists paint detailed works of art on agar. various strains of bacteria from the human skin and body cavities are grown on petri dishes. the microbes react and spread across carefully drawn patterns. Agar plates are used as a canvas, while pigmented or fluorescent bacteria and yeasts represent paint. in order to preserve a piece of microbial art after a sufficient incubation, the microbe culture is sealed with epoxy. In the biosummit, i had the opportunity to take a workshop on agar art, that was mindblowing. Scientists have discovered a new canvas: agar plates. their medium? bacteria! in recent years, scientists have begun to blend traditional art forms with microbiology by painting with living organisms.
Agar Art Painting With Bacteria Workshop March 1 3 2018 Events Microbiologists paint detailed works of art on agar. various strains of bacteria from the human skin and body cavities are grown on petri dishes. the microbes react and spread across carefully drawn patterns. Agar plates are used as a canvas, while pigmented or fluorescent bacteria and yeasts represent paint. in order to preserve a piece of microbial art after a sufficient incubation, the microbe culture is sealed with epoxy. In the biosummit, i had the opportunity to take a workshop on agar art, that was mindblowing. Scientists have discovered a new canvas: agar plates. their medium? bacteria! in recent years, scientists have begun to blend traditional art forms with microbiology by painting with living organisms.
Agar Art Painting With Bacteria Workshop March 1 3 2018 Events In the biosummit, i had the opportunity to take a workshop on agar art, that was mindblowing. Scientists have discovered a new canvas: agar plates. their medium? bacteria! in recent years, scientists have begun to blend traditional art forms with microbiology by painting with living organisms.

Agar Art Painting With Bacteria Workshop March 1 3 2018 Events
Comments are closed.